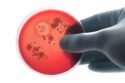

Hospitais superlotados. Longas internações. Sistemas de saúde colapsados. Pacientes entubados. Trata-se de um cenário que se repetiu ao redor de todo o globo desde o começo da pandemia de Covid-19, causada pelo coronavírus (Sars-CoV-2).
Esta conjuntura favoreceu, também, a proliferação de bactérias resistentes a antibióticos. O número de superbactérias identificadas do Brasil quase quadruplicou nesse período.
Os dados são do Laboratório de Pesquisa em Infecção Hospitalar do Instituto Oswaldo Cruz (IOC/Fiocruz). Em 2019, o laboratório, que faz parte da Sub-rede Analítica de Resistência Microbiana em Serviços de Saúde (Sub-rede RM) da Agência Nacional de Vigilância Sanitária (Anvisa), detectou pouco mais de mil.
Em 2020, o número se aproximou de duas mil bactérias resistentes enviadas para análise. Já até o momento, em 2021, foram 4.276 amostras recebidas no laboratório da Fiocruz. O número inédito e atualizado foi revelado ao Metrópoles pelos pesquisadores.
3 Cards_Galeria_de_Fotos (1)
Apesar da queda de casos de Covid registrados no Brasil, ainda não é hora de abrir mão dos cuidados para conter a proliferação do vírus, principalmente com a nova variante Ômicron em circulação pelo país
Viktor Forgacs/ Unsplash
***como-se-proteger-da-covid
A Fundação Oswaldo Cruz (Fiocruz) elaborou cartilha com recomendações para que as festividades possam ser celebradas em segurança
Marko Geber/ Metrópoles
***como-se-proteger-da-covid (3)
A principal orientação é estar com a vacinação completa para garantir a sua saúde e das pessoas que você ama. Caso ainda não tenha tomado alguma dose, basta ir ao posto de saúde para receber o imunizante o quanto antes
Gustavo Alcântara/Metrópoles
***como-se-proteger-da-covid (3)
A preferência por espaços ventilados também ajuda a conter a propagação do vírus, uma vez que o Sars-CoV-2, causador da Covid-19, permanece suspenso no ar em pequenas gotículas respiratórias
Vitranc/ Getty Images
***como-se-proteger-da-covid (3)
Embora as festas de fim de ano sejam, normalmente, comemoradas com familiares, a utilização do álcool 70% também é indispensável. Por isso, ofereça o produto na entrada do evento e deixe recipientes com o item espalhados pelo ambiente
By Tang Ming Tung / Getty Images
***como-se-proteger-da-covid (3)
É importante que toalhas descartáveis substituam toalhas de pano, pois, dessa forma, o contato de várias pessoas com um único objeto será evitado
Getty Images
***como-se-proteger-da-covid (3)
Segundo a Fiocruz, o uso correto da máscara também é importante. Portanto, ter máscaras extras e guardar a que está utilizando em saco plástico enquanto se alimenta é essencial
Getty Images
***como-se-proteger-da-covid (3)
Caso vá viajar, além de ter tomado todas as doses do imunizante e levar consigo o cartão de vacinação, a Fiocruz recomenda a realização de teste 2 ou 3 dias antes do passeio
Vinícius Schmidt/Metrópoles
***como-se-proteger-da-covid (3)
Para se proteger durante percurso em avião ou ônibus, mantenha as mãos higienizadas com água e sabão, quando possível, e utilize álcool em gel. Não esqueça da máscara com boa vedação. A PFF2 é uma das indicadas
By Tang Ming Tung / Getty Images
***como-se-proteger-da-covid (3)
Caso apresente algum sintoma da Covid-19, tenha tido contato nos últimos 14 dias com alguém infectado ou em caso de diagnóstico positivo, não encontre outras pessoas. Essa atitude é importante para garantir a saúde de todos
Daniel Allan/ Getty Images
***como-se-proteger-da-covid (3)
A permanência em casa para não vacinados também é recomendada
Reprodução/Instagram
0
A rede da Anvisa funciona da seguinte forma: os hospitais enviam as amostras para os Laboratórios Centrais (Lacens). Daí, o material é enviado para os locais que participam da rede. Entre eles, está o Laboratório de Pesquisa em Infecção Hospitalar da Fiocruz, onde atua a pesquisadora e chefe da unidade, Ana Paula Assef.
“ Vários órgãos de saúde já tinham essa preocupação antes da pandemia, porque bactérias multirresistentes já são problema nesses hospitais”, explica. “Com a pandemia, tivemos muitos pacientes internados por muito tempo com procedimentos invasivos, como a intubação. Acaba favorecendo o surgimento de infecções secundárias que são tratadas com antibióticos”
A alta utilização destes medicamentos não foi desnecessária, esclarece Ana Paula, mas “o excesso de uso de antibióticos, de forma geral, acaba fazendo com que as bactérias fiquem mais resistentes e se multipliquem mais”.
A preocupação com as superbactérias, anterior à pandemia, ganha graves contornos em meio à emergência sanitária. Em nota técnica publicada em agosto sobre o tema, a Anvisa cita um triste caso ocorrido em uma unidade de terapia intensiva (UTI) de Maringá.
Infectados por bactéria A. baumanii resistente a antibióticos, sete pacientes antes internados por Covid-19 , de dez, morreram. De acordo com a Organização Pan-Americana de Saúde (Opas), diferentes países do continente americano tem notificado surtos de infecções resistentes a medicamentos.
Dados da Opas apontam que cerca de 90% dos pacientes hospitalizados com Covid-19 nas Américas receberam antibióticos, ao passo que apenas 7% deles precisaram, de fato, dos medicamentos para “tratar infecção secundária”.
A OPAS e a nota técnica da Anvisa ressaltam, ainda, o perigo dos medicamentos sem eficácia comprovada contra a Covid-19, que vêm sendo utilizados por uma parcela da população. É o caso do kit covid, amplamente divulgado pelo presidente Bolsonaro.
“Um outro fator contribuinte para o aumento da resistência microbiana no contexto da atual pandemia é o uso inadequado de agentes antimicrobianos, especialmente dos antibióticos de amplo espectro como azitromicina e levofloxacina, para tratamento da COVID19, uma vez que eles não são eficazes no tratamento de infecções virais”, destaca o documento da Anvisa.
A nota técnica GVIMS/GGTES/ANVISA nº 05/2021, intitulada “Orientações para prevenção e controle da disseminação de microrganismos multirresistentes em serviços de saúde no contexto da pandemia da Covid-19”, salienta algumas medidas para contenção do cenário.
São elas: a utilização correta de equipamentos de proteção individual (EPI’s), a higiene completa e correta das mãos, a intensificação da limpeza e desinfecção ambiental, os cuidados com equipamentos e objetos utilizados, o gerenciamento do uso de antibióticos e a prevenção da lesão por pressão, que aparecem na pele quando se permanece em uma mesma posição por muito tempo.
O post Número de superbactérias quase quadruplicou no Brasil durante pandemia apareceu primeiro em Metrópoles.